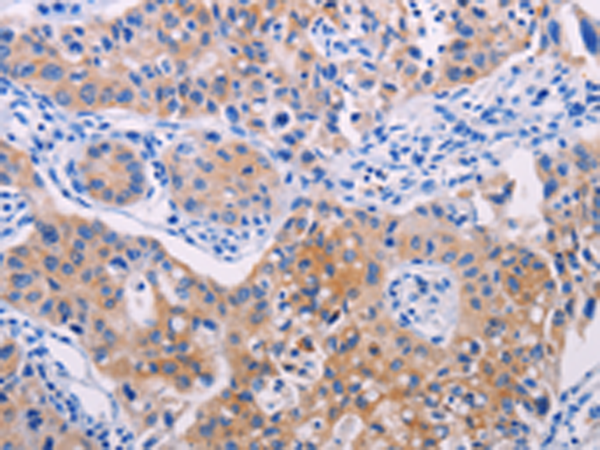

中文名稱:兔抗AGT/Angiotensin-1多克隆抗體
|
Background: |
The protein encoded by this gene, pre-angiotensinogen or angiotensinogen precursor, is expressed in the liver and is cleaved by the enzyme renin in response to lowered blood pressure. The resulting product, angiotensin I, is then cleaved by angiotensin converting enzyme (ACE) to generate the physiologically active enzyme angiotensin II. The protein is involved in maintaining blood pressure and in the pathogenesis of essential hypertension and preeclampsia. Mutations in this gene are associated with susceptibility to essential hypertension, and can cause renal tubular dysgenesis, a severe disorder of renal tubular development. Defects in this gene have also been associated with non-familial structural atrial fibrillation, and inflammatory bowel disease. |
|
Applications: |
ELISA, WB, IHC |
|
Name of antibody: |
AGT/Angiotensin-1 |
|
Immunogen: |
Synthetic peptide of human AGT/Angiotensin-1 |
|
Full name: |
Angiotensinogen (serpin peptidase inhibitor, clade A, member 8) |
|
Synonyms: |
ANHU; SERPINA8 |
|
SwissProt: |
P01019 |
|
ELISA Recommended dilution: |
2000-5000 |
|
IHC positive control: |
Human breast cancer and human lung cancer |
|
IHC Recommend dilution: |
25-100 |
|
WB Predicted band size: |
53 kDa |
|
WB Positive control: |
Human liver cancer tissue |
|
WB Recommended dilution: |
500-2000 |

購物車
幫助
021-54845833/15800441009
